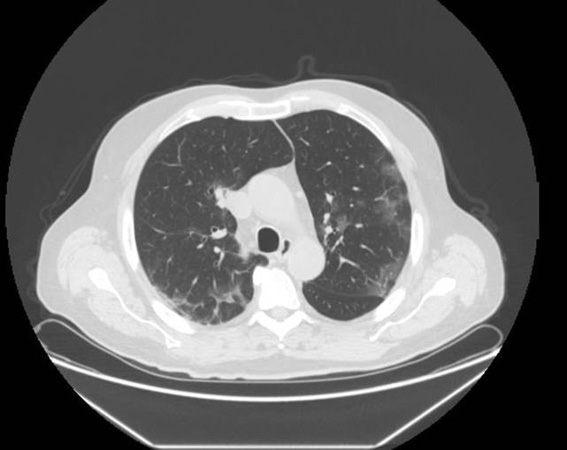
img_02-01.jpg

Coronavirus Disease 2019 (COVID-19): A Brief Report
Domenico Lorenzo Urso 1
1 Emergency Department - Spoke Hospital Corigliano-Rossano (CS), Italy
Abstract
Severe acute respiratory syndrome (“SARS-CoV-2”, previously provisionally named “2019 novel coronavirus” or “2019-nCoV”) disease (COVID-19) in China, at the end of 2019, resulted in a large global outbreak.
Among patients with pneumonia caused by SARS-CoV-2, fever is the most common symptom, followed by dry cough. Bilateral lung involvement with ground-glass opacities (GGOs) is the most common finding from computed tomography (CT) images of the chest.
At present, there are no specific antiviral drugs against SARS-CoV-2 infection for potential therapy of humans. Current treatments are mainly focused on symptomatic and respiratory support in patients with COVID-19. Preventive measures are the current strategy to limit the spread of cases.
The present report summarizes the point of the situation about this global emergency.
Keywords: SARS-CoV-2; Coronavirus; Pandemic; Pneumonia; Respiratory Support
CMI 2020; 14(1): 15-19
http://dx.doi.org/10.7175/cmi.v14i1.1467
Brief Report
Introduction
Since December 2019, an increasing number of cases of pneumonia of “unknown etiology” have been identified in Wuhan, a large city of 11 million people, in mainland China [1]. These patients were epidemiologically linked to Huanan Seafood Wholesale Market, where wild and live animals were sold and, on January 1, 2020, Wuhan Public Health Authorities shut it down. A week later, on January 7, 2020, a new Betacoronavirus was isolated from bronchoalveolar-lavage fluid samples of three patients with severe pneumonia. This virus was initially identified as “novel coronavirus 2019” (2019-nCoV) and the illness likely to have been caused by 2019-nCoV was named “novel coronavirus infected pneumonia” (NCIP) [2]. On February 11, 2020, the World Health Organization (WHO) announced a new name for the epidemic disease caused by 2019-nCoV: “coronavirus disease 2019” (COVID-19) [3]. The Coronaviridae Study Group (CSG) of the International Committee on Taxonomy of Viruses (ICTV) has renamed the previously provisionally named 2019-nCoV as “severe acute respiratory syndrome coronavirus-2” (SARS-CoV-2) [4]. The human-to-human transmission of SARS-CoV-2 is presumed to be primarily through droplets and fomites.
R0, used to measure the transmission potential of a communicable disease in epidemiology, is the average number of secondary infections produced by an infectious case in a population where everyone is susceptible [5]. Early epidemiologic studies estimate an R0 value of 2.2 [6] for SARS-CoV-2. Due to the progressive spread of the virus to over 110 countries, with more than 118,000 cases and over 4200 deaths, SARS-CoV-2 infection was declared a pandemic by WHO on March 11, 2020 [7].
Epidemiology
As of March 31, 2020, there have been 750,890 cases of COVID-19 globally, with 101,739 of those in Italy; there have been 36,405 confirmed deaths globally with 11,591 of those in Italy [8]. The Chinese Center for Disease Control and Prevention recently published the largest case series to date of COVID-19 in mainland China (72,314 cases, updated through February 11, 2020). Among a total of cases records:
Most patients were 30 to 79 years of age (87%), 1% were aged 9 years or younger, and 3% were aged 80 years or older. Most cases were classified as mild (81%), 14% as severe, and 5% as critical. The overall case-fatality rate (CFR) was 2.3% (1023 deaths among 44,672 confirmed cases). CFR was 8% in the group aged 70-79 years and 14.8% in the group aged 80 years and older. No deaths were reported among mild and severe cases. The CFR was 49.0% among critical cases. CFR was elevated among those with preexisting comorbid conditions: 10.5% for cardiovascular disease, 7.3% for diabetes, 6.3% for chronic respiratory disease, 6.0% for hypertension, and 5.6% for cancer [9,10].
Clinical features
According to WHO, a confirmed case of COVID-19 is a person with laboratory confirmation of infection with SARS-CoV-2, irrespective of clinical signs or symptoms (Box 1) [11].
Box 1. Definitions in COVID-19 [11]
Confirmed case
A confirmed case is a person with laboratory confirmation of infection with the COVID-19 virus, irrespective of clinical signs and symptoms
Probable case
A probable case is a suspected case for whom the report from laboratory testing for the COVID-19 virus is inconclusive
Suspected case
The symptoms of SARS-CoV-2 infection appear after an incubation period of approximately 5.2 days [12]. The main clinical manifestations of COVID-19 are fever (90% or more), dry cough (around 75%), and dyspnea (up to 50%). Other symptoms include headache, fatigue, sputum production, and hemoptysis. A small but significant subset has gastrointestinal symptoms [13-16]. The majority of infected people have uncomplicated or mild illness (81%), but some of them will develop severe illness (including dyspnea, respiratory frequency >30/min, blood oxygen saturation <93%, partial pressure of arterial oxygen to fraction of inspired oxygen ratio <300, and/or lung infiltrates >50% within 24 to 48 hours), which requires oxygen therapy (14%). A minority of them, around 5%, will require intensive care unit (ICU) treatment (due to respiratory failure, septic shock, and/or multiple organ dysfunction or failure) (Box 2) [9,17].
Box 2. Clinical syndromes associated with COVID-19 in adult [17]
Mild illness
Uncomplicated upper respiratory tract viral infection may have non-specific symptoms such as fever, fatigue, cough (with or without sputum production), anorexia, malaise, muscle pain, sore throat, dyspnea, nasal congestion, or headache. Rarely, patients may also present with diarrhea, nausea, and vomiting
Pneumonia
Pneumonia but no signs of severe pneumonia and no need for supplemental oxygen
Severe pneumonia
Fever or suspected respiratory infection, plus one of the following: respiratory rate >30 breaths/min; severe respiratory distress; or SpO2 ≤ 93% on room air
Acute respiratory distress syndrome (ARDS)
Sepsis
Life-threatening organ dysfunction caused by a dysregulated host response to suspected or proven infection. Signs of organ dysfunction include: altered mental status, difficult or fast breathing, low oxygen saturation, reduced urine output, fast heart rate, weak pulse, cold extremities or low blood pressure, skin mottling, or laboratory evidence of coagulopathy, thrombocytopenia, acidosis, high lactate, or hyperbilirubinemia
Septic shock
Persisting hypotension despite volume resuscitation, requiring vasopressors to maintain MAP ≥ 65 mmHg and serum lactate level > 2 mmol/L
Figure 1. Chest CT: early features of COVID-19 pneumonia. Multiple patchy pure ground glass opacities (GGOs) may be seen.
The most common diagnosis in severe COVID-19 patients is severe pneumonia [9].
The currently available data suggest that the most frequent abnormalities were lymphopenia (35-75% of cases), increased values of C-reactive protein (75-93% of cases), lactate dehydrogenase (27-92% of cases), erythrocyte sedimentation rate (up to 85% of cases) and D-dimer (36-43% of cases), as well as low concentrations of serum albumin (50-98% of cases), and hemoglobin (41-50%) [18].
COVID-19 pneumonia is common. The early chest CT features are multiple patchy pure ground glass opacities (GGOs) or GGOs with consolidation in the peripheral zone of the lung, often with vascular thickening and the crazy paving pattern, air bronchogram sign, or halo sign (Figure 1) [19].
Lung ultrasonography is useful to manage COVID-19 with respiratory involvement due to several characteristics: safety, repeatability, absence of radiation, low cost, and point-of-care use. Chest CT may be performed in cases where lung ultrasonography is not sufficient to answer the clinical question. Using a 12-zone method, characteristic findings include thickening of the pleural line with pleural line irregularity, B lines in a variety of patterns including focal, multifocal, and confluent, consolidations in a variety of patterns including multifocal small, non-translobar, and translobar with occasional mobile air bronchograms [20].
Diagnosis
Confirmation of cases of COVID-19 is based on real-time reverse transcription polymerase chain reaction (rRT-PCR). At minimum, respiratory material should be collected from the upper respiratory specimens (nasopharyngeal and oropharyngeal swab or wash in ambulatory patients) and/or from the lower respiratory specimens (sputum if produced and/or endotracheal aspirate or bronchoalveolar lavage in patients with more severe respiratory disease) [21].
Treatment
Nowadays, there is no evidence from randomized clinical trials to support specific drug treatment against the new coronavirus in suspected or confirmed cases. Therefore, current treatments mainly focus on symptomatic and respiratory support.
Infection control and prevention
The WHO recommend infection control interventions to reduce the general risk of transmission of acute respiratory infection with SARS-CoV-2, including avoiding close contact with people suffering from acute respiratory infections, frequent hand washing especially after direct contact with ill people or their environment, and avoiding unprotected contact with farm or wild animals [22].
Conclusions
The outbreak of SARS-CoV-2 is a clinical threat to the general population and healthcare workers worldwide. Scientists have made progress in the characterization of the novel coronavirus but, at present, there is not a specific treatment. Preventive measures are the current strategy to limit the spread of cases.
Key Points
Funding
This article has been published without the support of sponsors.
Conflicts of interests
The author declares he has no competing financial interests concerning the topics of this article.
References
1. Lu H, Stratton CW, Tang YW, et al. Outbreak of pneumonia of unknown etiology in Wuhan China: the mystery and the miracle. J Med Virol 2020; 92: 401-2; https://doi.org/10.1002/jmv.25678
2. Zhu N, Zhang D, Wang W, et al. A Novel Coronavirus from Patients with Pneumonia in China, 2019. N Engl J Med 2020; 382: 727-33; https://doi.org/10.1056/NEJMoa2001017
3. World Health Organization, WHO Director-General’s Remarks at the Media Briefing on 2019-nCoV on 11 February 2020. (2020). Available at https://www.who.int/dg/speeches/detail/who-director-general-s-remarks-at-the-media-briefing-on-2019-ncov-on-11-february-2020 (last accessed April 2020)
4. Gorbalenya AE, Baker SC, Baric RS, et al. The species Severe acute respiratory syndrome-related coronavirus: classifying 2019-nCoV and naming it SARS-CoV-2. Nat Microbiol (2020); 5: 536-44; https://doi.org/10.1038/s41564-020-0695-z
5. Delamater PL, Street EJ, Leslie TF, et al. Complexity of the Basic Reproduction Number (R0). Emerg Infect Dis 2019; 25: 1-4; https://doi.org/10.3201/eid2501.171901
6. Riou J, Althaus CL. Pattern of early human-to-human transmission of Wuhan 2019 novel coronavirus (2019-nCoV), December 2019 to January 2020. Eurosurveillance 2020; 25: 2000058; https://doi.org/10.2807/1560-7917.ES.2020.25.4.2000058
7. World Health Organization, WHO Director-General’s Remarks at the Media Briefing on COVID-19 on 11 March 2020. (2020). Available at https://www.who.int/dg/speeches/detail/who-director-general-s-opening-remarks-at-the-media-briefing-on-covid-19---11-march-2020 (last accessed April 2020)
8. World Health Organization, Coronavirus Disease 2019 (COVID-19) Situation Report 71. (2020). Available at https://www.who.int/docs/default-source/coronaviruse/situation-reports/20200331-sitrep-71-covid-19.pdf?sfvrsn=4360e92b_4 (last accessed April 2020)
9. Novel Coronavirus Pneumonia Emergency Response Epidemiology Team. Vital surveillances: the epidemiological characteristics of an outbreak of 2019 novel coronavirus diseases (COVID-19) - China, 2020. China CDCWeekly. Available at http://www.ourphn.org.au/wp-content/uploads/20200225-Article-COVID-19.pdf (last accessed April 2020)
10. Wu Z, McGoogan JM. Characteristics of and Important Lessons From the Coronavirus Disease 2019 (COVID-19) Outbreak in China: Summary of a Report of 72 314 Cases From the Chinese Center for Disease Control and Prevention. JAMA Published online February 24, 2020; https://doi.org/10.1001/jama.2020.2648
11. Global Surveillance for human infection with coronavirus disease (COVID-19) Interim guidance 27 February 2020 (2020). Available at https://www.who.int/publications-detail/global-surveillance-for-human-infection-with-novel-coronavirus-(2019-ncov) (last accessed April 2020)
12. Li Q, Med M, Guan X, et al. Early transmission dynamics in Wuhan, China, of novel coronavirus-infected pneumonia. N Engl J Med 2020; 382: 1199-207; https://doi.org/10.1056/NEJMoa2001316
13. Huang C, Wang Y, Li X, et al. Clinical features of patients infected with 2019 novel coronavirus in Wuhan, China. Lancet 2020; 395: 497-506; https://doi.org/10.1016/S0140-6736(20)30183-5
14. Zhu N, Zhang D, Wang W, et al. A novel coronavirus from patients with pneumonia in China, 2019. N Engl J Med 2020; 382: 727-33; https://doi.org/10.1056/NEJMoa2001017
15. Chen N, Zhou M, Dong X, et al. Epidemiological and clinical characteristics of 99 cases of 2019 novel coronavirus pneumonia in Wuhan, China: a descriptive study. Lancet 2020; 395: 507-13; https://doi.org/10.1016/S0140-6736(20)30211-7
16. Jiang F, Deng L, Zhang L, et al. Review of the Clinical Characteristics of Coronavirus Disease 2019 (COVID-19). J Gen Intern Med (2020); Published 4 March 2020; https://doi.org/10.1007/s11606-020-05762-w
17. Clinical management of severe acute respiratory infection (SARI) when COVID-19 disease is suspected. Interim guidance 13 March 2020 (2020). Available at https://www.who.int/publications-detail/clinical-management-of-severe-acute-respiratory-infection-when-novel-coronavirus-(ncov)-infection-is-suspected (last accessed April 2020)
18. Lippi G, Plebani M. Laboratory abnormalities in patients with COVID-2019 infection, Clinical Chemistry and Laboratory Medicine (CCLM) (published online ahead of print 3 March 2020), 20200198; https://doi.org/10.1515/cclm-2020-0198
19. Han R, Huang L, Jiang H, et al. Early Clinical and CT Manifestations of Coronavirus Disease 2019 (COVID-19) Pneumonia. AJR Am J Roentgenol 2020: 1-6; https://doi.org/10.2214/AJR.20.22961
20. Peng QY, Wang XT, Zhang LN; Chinese Critical Care Ultrasound Study Group (CCUSG). Findings of lung ultrasonography of novel corona virus pneumonia during the 2019-2020 epidemic. Intensive Care Med Published 12 March 2020; https://doi.org/10.1007/s00134-020-05996-6
21. World Health Organization. (2020). Laboratory testing for coronavirus disease 2019 (COVID-19) in suspected human cases: interim guidance, 2 March 2020. World Health Organization 2020. Available at https://apps.who.int/iris/handle/10665/331329 (last accessed April 2020)
22. World Health Organization. (2020). Infection prevention and control during healthcare when COVID-19 is suspected. Available at https://www.who.int/emergencies/diseases/novel-coronavirus-2019/technical-guidance/infection-prevention-and-control (last accessed April 2020)